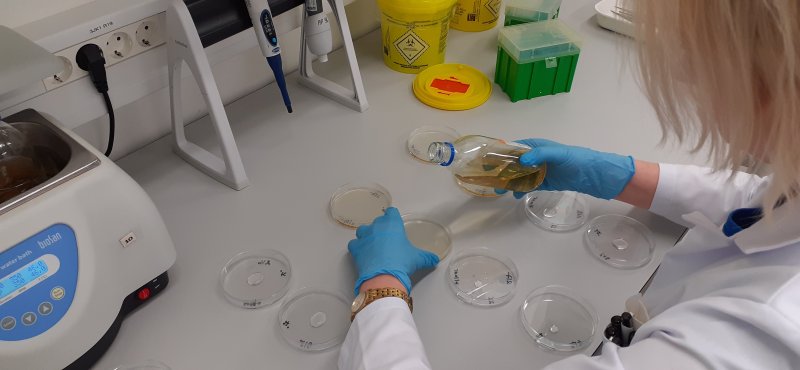

Terviseameti nakkushaiguste laboris tehtud veeanalüüsid kinnitasid Kuressaare joogivee saastumise Escherichia coli bakteriga. Kuivõrd Kuressaare veevärgi poolt võetud kordusproovides esines samuti viiteid saastumisele, tuleb joogiks jätkuvalt eelistada pudelivett ning kraanivett enne tarvitamist keeta vähemalt 10 minutit.
Terviseameti nakkushaiguste labori juhataja Janne Pullat selgitas, et joogivees esinenud kolibakteri serotüübi määramiseks viidi täiendavalt läbi PCR-analüüs, mille tulemusel on tegemist E.coli vormiga, mis ei ole kõige toksilisem tüüp, kuid langeb kokku patsientidel esinenud sümptomitega. „Joogivees esinenud patogeenide tuvastamiseks on vajalik lasta bakteritel labori tingimustes vähemalt ööpäeva kasvada ning seetõttu võtab lõpliku kinnituse saamine aega. Täna jätkab labor patsientidelt võetud kliiniliste proovide analüüsi, kelle puhul vaadatakse, kas nakatumine on seotud sama nakkusallikaga,“ ütles Pullat.
Terviseameti nakkushaiguste epidemioloogia osakonna juhataja Kärt Sõber tõi välja, et viimase ööpäeva jooksul on Kuressaare haiglasse pöördunute arv langenud ja ka kiirabi kutsete arv on normaliseerunud. „Olukord siiski lahenenud ei ole, sest Kuressaare veevärk tuvastas enda võetud kordusproovides samuti kolibakteri esinemise. Jätkuvalt on vajalik kraanivee põhjalik läbikeetmine, et hävitada võimalikud bakterid, mis on trassi alles jäänud ja jõuavad torustiku kaudu inimese koju. Kohalik veeettevõtja jätkab küll torustikes vee vahetamist ning kloori lisamist, et probleem kõrvaldada, kuid see võib veel mitu päeva aega võtta, kuni saasteallikas on lõplikult hävitatud,“ rääkis Sõber.
Kokkuleppe kohaselt jätkab veeettevõtja proovide võtmist iga päev, kuni joogivee probleem on lahenenud. Ohtlikuks osutub saastunud vesi alla neelates, kuid inimese nakatumise puhul võib bakteriaalne nakkus edasi kanduda ka perekondlikult, kui näiteks enne toidu valmistamist ja tualeti kasutamise järel pestakse käsi lohakalt. Niisiis tasub hoolas olla ka haigete pereliikmete eest hoolitsemisel.
Terviseamet viib juhtunuga seoses läbi riiklikku järelevalvemenetlust, mille eesmärk on välja selgitada kõik Kuressaare joogivee saastumisega seotud asjaolud. Ühtlasi peab järelevalve käigus selguma, kas järgiti kõiki joogivee käitlemisega seotud reegleid.